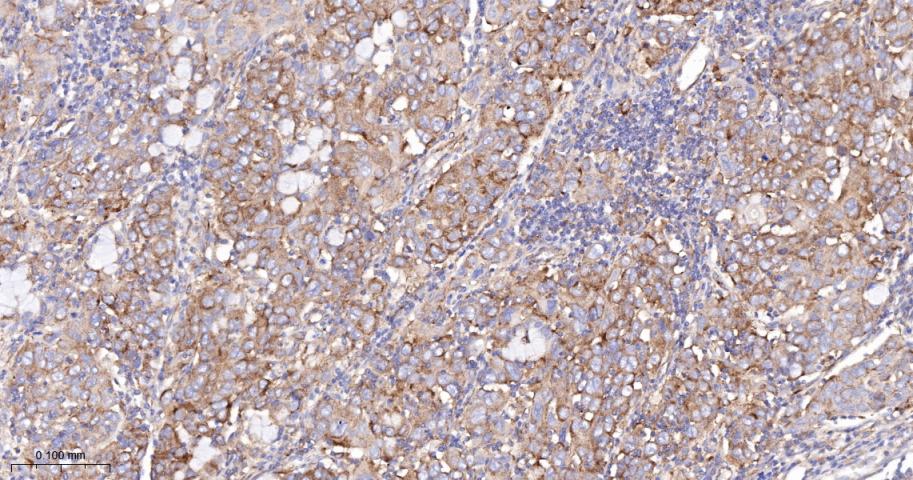
产品细节图片4
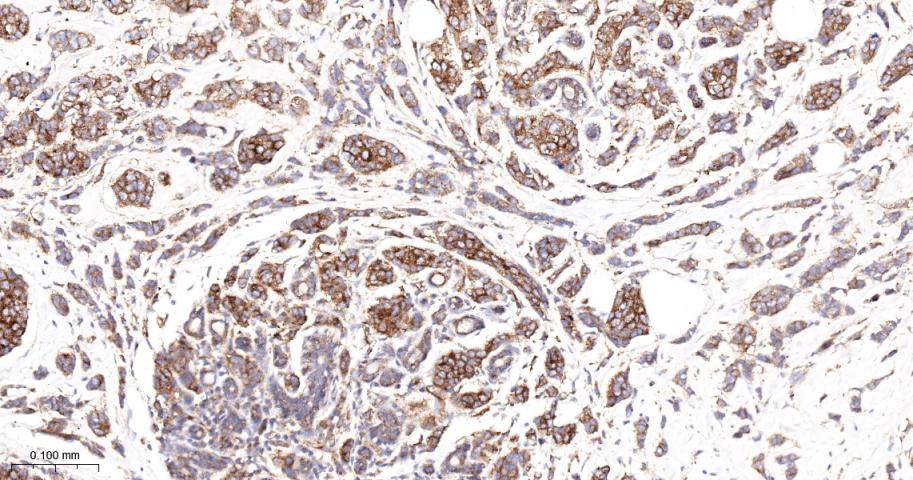
产品细节图片5

相关产品推荐更多 >
万千商家帮你免费找货
0 人在求购买到急需产品
- 详细信息
- 文献和实验
- 技术资料
- 应用范围:
产品信息以Bioss网站为准
- 规格:
50ul/100ul/25ul
| 规格: | 50ul | 产品价格: | ¥1400.0 |
|---|---|---|---|
| 规格: | 100ul | 产品价格: | ¥2500.0 |
| 规格: | 25ul | 产品价格: | ¥800.0 |
| 产品编号 | bsm-52338R |
| 英文名称 | VEGFR1 Recombinant Rabbit mAb |
| 中文名称 | 血管内皮生长因子受体1重组兔单抗 |
| 英文别名 | Vascular endothelial growth factor receptor 1; VEGF-R1; VEGFR-1; VEGF Receptor 1; FLT-1; vascular permeability factor receptor; vascular endothelial growth factor receptor; vascular endothelial growth factor receptor-1; fms-related tyrosine kinase 1; vascular endothelial growth factor/vascular permeability factor receptor; AI323757; FLT; FLT1; sFlt1; VGFR1_HUMAN; VGFR1_MOUSE. |
| 产品应用 | WB=1:500-2000, IHC-P=1:100-500, IHC-F=1:100-500, IF=1:100-500 Not yet tested in other applications. |
| 交叉反应 | Human, Mouse, Rat |
| 抗体来源 | Rabbit |
| 免疫原 | A synthesized peptide derived from human VEGF Receptor 1 |
| 亚型 | IgG |
| 性状 | Liquid |
| 纯化方法 | affinity purified by Protein A |
| 克隆类型 | Recombinant |
| 理论分子量 | 147 kDa |
| 浓度 | 1mg/ml |
| 储存液 | 0.01M TBS (pH7.4) with 1% BSA, 0.02% Proclin300 and 50% Glycerol. |
| 研究领域 | Cancer > Cancer Metabolism > Response to hypoxia Cancer > Growth factors > VEGF Cancer > Invasion/microenvironment > Angiogenesis > Angiogenic growth factors Cancer > Oncoproteins/suppressors > Oncoproteins > Growth factors Cardiovascular > Angiogenesis > Endothelial Cell Markers Cardiovascular > Angiogenesis > Growth Factors > VEGF > VEGF Receptors Cardiovascular > Vasculature > Endothelium Metabolism > Pathways and Processes > Metabolism processes > Hypoxia Metabolism > Types of disease > Cancer Signal Transduction > Growth Factors/Hormones > VEGF Signal Transduction > Protein Phosphorylation > Tyrosine Kinases |
| 亚基 | Tyrosine-protein kinase that acts as a cell-surface receptor for VEGFA, VEGFB and PGF, and plays an essential role in the development of embryonic vasculature, the regulation of angiogenesis, cell survival, cell migration, macrophage function, chemotaxis, and cancer cell invasion. May play an essential role as a negative regulator of embryonic angiogenesis by inhibiting excessive proliferation of endothelial cells. Can promote endothelial cell proliferation, survival and angiogenesis in adulthood. Its function in promoting cell proliferation seems to be cell-type specific. Promotes PGF-mediated proliferation of endothelial cells, and proliferation of some types of cancer cells, but does not promote proliferation of normal fibroblasts. Has very high affinity for VEGFA and relatively low protein kinase activity; may function as a negative regulator of VEGFA signaling by limiting the amount of free VEGFA and preventing its binding to KDR. Modulates KDR signaling by forming heterodimers with KDR. Ligand binding leads to the activation of several signaling cascades. Activation of PLCG1 leads to the production of the cellular signaling molecules diacylglycerol and inositol 1,4,5-trisphosphate and the activation of protein kinase C. Mediates phosphorylation of PIK3R1, the regulatory subunit of phosphatidylinositol 3-kinase, leading to the activation of phosphatidylinositol kinase and the downstream signaling pathway. Mediates activation of MAPK1/ERK2, Interacts with VEGFA, VEGFB and PGF. Monomer in the absence of bound VEGFA, VEGFB or PGF. Homodimer in the presence of bound VEGFA, VEGFB and PGF. Can also form a heterodimer with KDR.Interacts (when tyrosine phosphorylated) with CBL, CRK, GRB2, NCK1,PIK3R1, PLCG1 and PTPN11. Interacts with GNB2L1/RACK1. Identified in a complex with CBL and CD2AP. |
| 亚细胞定位 | Isoform 1: Cell membrane; Single-pass type I membrane protein. Endosome. Note=Autophosphorylation promotes ubiquitination and endocytosis;Isoform 2: Secreted;Isoform 3: Secreted;Isoform 4: Secreted;Isoform 5: Cytoplasm (Potential);Isoform 6: Cytoplasm (Potential);Isoform 7: Cytoplasm (Potential). |
| 组织特异性 | Detected in normal lung, but also in placenta,liver, kidney, heart and brain tissues. Specifically expressed in most of the vascular endothelial cells, and also expressed in peripheral blood monocytes. Isoform 2 is strongly expressed in placenta. Isoform 3 is expressed in corneal epithelial cells (at protein level). Isoform 3 is expressed in vascular smooth muscle cells (VSMC). |
| 翻译后修饰 | N-glycosylated. Ubiquitinated after VEGFA-mediated autophosphorylation, leading to proteolytic degradation. Autophosphorylated on tyrosine residues upon ligand binding. Autophosphorylation occurs in trans, i.e. one subunit of the dimeric receptor phosphorylates tyrosine residues on the other subunit. Phosphorylation at Tyr-1169 is important for interaction with PLCG1. Phosphorylation at Tyr-1213 is important for interaction with PIK3R1, PTPN11, GRB2, and PLCG1. Phosphorylation at Tyr-1331 is important for endocytosis and for interaction with CBL, NCK1 and CRK. |
| 相似性 | Belongs to the protein kinase superfamily. Tyr protein kinase family. CSF-1/PDGF receptor subfamily.Contains 7 Ig-like C2-type (immunoglobulin-like)domains.Contains 1 protein kinase domain. |
| 功能 | Following activation by double-stranded RNA in the presence of ATP, the kinase becomes autophosphorylated and can catalyze the phosphorylation of the translation initiation factor EIF2S1, which leads to an inhibition of the initiation of protein synthesis. Double-stranded RNA is generated during the course of a viral infection. |
| 保存条件 | Shipped at 4℃. Store at -20℃ for one year. Avoid repeated freeze/thaw cycles. |
| 注意事项 | This product as supplied is intended for research use only, not for use in human, therapeutic or diagnostic applications. |
| 背景资料 | VEGF Receptor 1 (also known as FLT) belongs to the src gene family and shows tyrosine protein kinase activity that is important for the control of cell proliferation and differentiation. The protein acts as a receptor for VEGF, VEGFB and PGF. An alternatively spliced form of the gene produces a soluble protein (sFlt1) which binds vascular endothelial growth factor (VEGF) with high affinity. sFlt1 has a higher affinity for VEGF indicating that it may function as an inhibitor in the VEGF response. VEGF Receptor 1 is specifically expressed in most vascular endothelial cells and peripheral blood monocytes. |
| 应用 | 推荐稀释比例 |
| {WB} | {1:500-2000} |
| {IHC-P} | {1:100-500} |
| {IHC-F} | {1:100-500} |
| {IF} | {1:100-500} |

风险提示:丁香通仅作为第三方平台,为商家信息发布提供平台空间。用户咨询产品时请注意保护个人信息及财产安全,合理判断,谨慎选购商品,商家和用户对交易行为负责。对于医疗器械类产品,请先查证核实企业经营资质和医疗器械产品注册证情况。
文献和实验[IF={{ 3.4 }}] {Xinran Xu. et al. Epigallocatechin gallate (EGCG) alleviates inflammation and endothelial dysfunction and improves pregnancy outcomes in preeclampsia (PE)-like rats via eNOS/Nrf2/HO-1 pathway. J REPROD IMMUNOL. 2024 May;:104263} {IHC,WB} {Rat}
[IF={{ 3.4 }}] {Xiangju Gao. et al. The common pathogenesis of nodular goiter in both sexes: An exploration into gene expression and signaling pathways. HELIYON. 2024 Jul;10:} {IF,WB} {Rat}
到 PVDF 膜上,同时减少蛋白不必要降解,这对于最终获得清晰、可信结果也是需要考虑因素。抗体信息:1.ACC1, Recombinant Rabbit monoclonal IgG. HuaAn. HuaAn biotechnology , inc.2.ATGL, Mouse mAb IgG1, Cat#:RT1058. HuaAn biotechnology , inc.3.p-PERK(Thr981), Rabbit Polyclonal IgG primary antibodies, Cat
The OP9-DL1 System: Generation of T-Lymphocytes from Embryonic or Hematopoietic Stem Cells In Vitro
al. 2006b ). MATERIALS Reagents Anti-CD24 monoclonal antibody (mAb) (J11d clone) (for Protocol 3) Use either culture supernatant that contains anti-CD24 mAb or purified anti-CD24 mAb (see Step 55). BDPharmLyse (red blood cell lysing
技术资料暂无技术资料 索取技术资料









